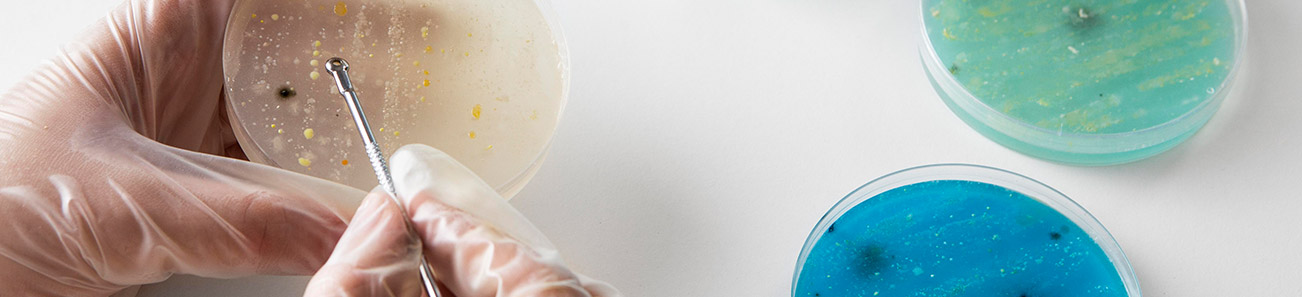
251113_식품환경연구센터_항균・항곰팡이-시험_03

항균・항곰팡이 시험
항균・항곰팡이 시험
목적 및 개요
· 각종 공업 제품 또는 재료의 세균 ・ 효모 ・ 곰팡이 등에 대한 항균력을 조사하는 시험이며 정량시험법과 정성시험법이 있습니다.
· 시험 목적에 따라 AATCC TM100, JIS L 1902, JIS Z 2801 등 각종 규격시험법을 실시합니다.
시험 균종
세균
Staphylococcus aureus, Escherichia coli, Pseudomonas aeruginosa 등
효모
Candida albicans 등
곰팡이
Aspergillus brasiliensis 등
시험기간
· 검체 도착 후 1-3주 소요
식품환경연구센터에서는
식품 · 화장품 · 의약품 · 생활용품 · 생활환경 · 제조환경 등
다양한 산업 분야의 미생물 관련 문제 해결과 활용 방안을 함께 고민합니다.
